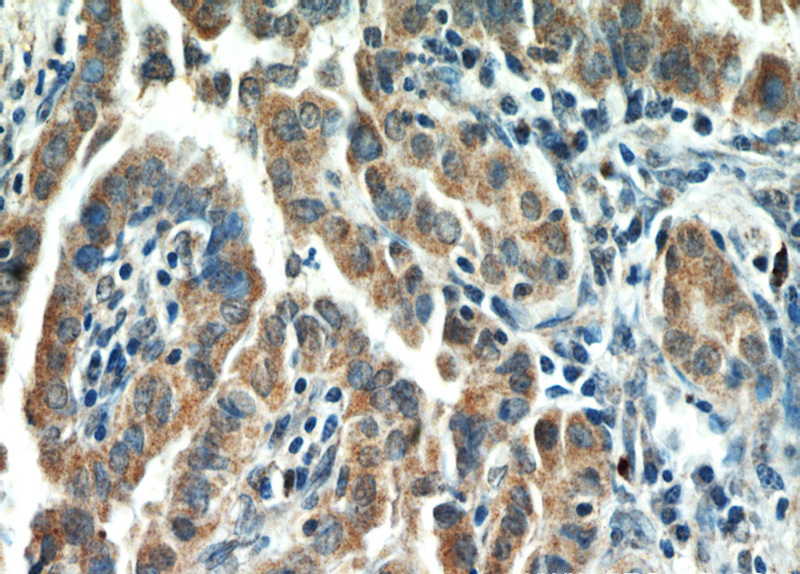
Immunohistochemical of paraffin-embedded human thyroid cancer using Catalog No:111345(HIF1A antibody) at dilution of 1:50 (under 40x lens)

-
Product Name
HIF1a antibody
- Documents
-
Description
HIF1a Rabbit Polyclonal antibody. Positive WB detected in Cobalt Chloride treated HeLa cells, HeLa cells, mouse small intestine tissue. Positive IF detected in Hela cells. Positive IHC detected in human thyroid cancer tissue, human heart tissue, human kidney tissue. Positive FC detected in HeLa cells. Observed molecular weight by Western-blot: 120 kDa
-
Tested applications
ELISA, IHC, IF, FC, WB
-
Species reactivity
Human,Mouse,Rat; other species not tested.
-
Alternative names
ARNT interacting protein antibody; bHLHe78 antibody; HIF 1 alpha antibody; HIF 1alpha antibody; HIF1 antibody; HIF1 ALPHA antibody; HIF1A antibody; Member of PAS protein 1 antibody; MOP1 antibody; PASD8 antibody
-
Isotype
Rabbit IgG
-
Preparation
This antibody was obtained by immunization of HIF1a recombinant protein (Accession Number: NM_001530). Purification method: Antigen affinity purified.
-
Clonality
Polyclonal
-
Formulation
PBS with 0.02% sodium azide and 50% glycerol pH 7.3.
-
Storage instructions
Store at -20℃. DO NOT ALIQUOT
-
Applications
Recommended Dilution:
WB: 1:200-1:1000
IHC: 1:20-1:200
IF: 1:10-1:100
-
Validations

Cobalt Chloride treated HeLa cells were subjected to SDS PAGE followed by western blot with Catalog No:111345(HIF1a Antibody) at dilution of 1:300

Immunofluorescent analysis of Hela cells, using HIF1A antibody Catalog No:111345 at 1:25 dilution and Rhodamine-labeled goat anti-rabbit IgG (red).

Immunohistochemical of paraffin-embedded human thyroid cancer using Catalog No:111345(HIF1A antibody) at dilution of 1:50 (under 10x lens)
Immunohistochemical of paraffin-embedded human thyroid cancer using Catalog No:111345(HIF1A antibody) at dilution of 1:50 (under 40x lens)

1X10^6 HeLa cells were stained with 0.2ug HIF1a antibody (Catalog No:111345, red) and control antibody (blue). Fixed with 90% MeOH blocked with 3% BSA (30 min). Alexa Fluor 488-congugated AffiniPure Goat Anti-Rabbit IgG(H+L) with dilution 1:1000.
-
Background
HIF1, the major regulator of the cellular responses to hypoxia, consists of an oxygen-sensitive subunit, HIF1alpha (HIFA), and an oxygen-insensitive subunit, HIF1beta (arylhydrocarbon receptor nuclear transporter [ARNT]). Although the mRNA is constitutively and ubiquitously expressed and transcribed, the HIF1A protein is rapidly degraded in the presence of oxygen. The half-life of HIF1A under ambient oxygeconditions is less than 5 min. Both hypoxic conditions and chemical hydroxylase inhibitors (such as desferrioxamine and cobalt) inhibit HIF-1α degradation and lead to its stabilization. In addition, HIF-1α can be induced in an oxygen-independent manner by various cytokines through the PI3K-AKT-mTOR pathway.
-
References
- Lin J, Qin X, Zhu Z. FHL family members suppress vascular endothelial growth factor expression through blockade of dimerization of HIF1α and HIF1β. IUBMB life. 64(11):921-30. 2012.
- Qu K, Yan Z, Wu Y. Transarterial chemoembolization aggravated peritumoral fibrosis via hypoxia-inducible factor-1α dependent pathway in hepatocellular carcinoma. Journal of gastroenterology and hepatology. 30(5):925-32. 2015.
- Hu T, He N, Yang Y, Yin C, Sang N, Yang Q. DEC2 expression is positively correlated with HIF-1 activation and the invasiveness of human osteosarcomas. Journal of experimental & clinical cancer research : CR. 34:22. 2015.
- Chen Z, Zhang Y, Jia C. mTORC1/2 targeted by n-3 polyunsaturated fatty acids in the prevention of mammary tumorigenesis and tumor progression. Oncogene. 33(37):4548-57. 2014.
- Peng B, Liu F, Han R. Dynamic metabolic change is indicative of inflammation-induced transformation of hepatic cells. The international journal of biochemistry & cell biology. 66:45-58. 2015.
- Liu F, Wang B, Li L. Low-Dose Cadmium Upregulates VEGF Expression in Lung Adenocarcinoma Cells. International journal of environmental research and public health. 12(9):10508-21. 2015.
- Liu F, Zhang W, You X. The oncoprotein HBXIP promotes glucose metabolism reprogramming via downregulating SCO2 and PDHA1 in breast cancer. Oncotarget. 6(29):27199-213. 2015.
- Shan X, Wang D, Chen J. Necrosis degree displayed in computed tomography images correlated with hypoxia and angiogenesis in breast cancer. Journal of computer assisted tomography. 37(1):22-8. 2013.
Related Products / Services
Please note: All products are "FOR RESEARCH USE ONLY AND ARE NOT INTENDED FOR DIAGNOSTIC OR THERAPEUTIC USE"
